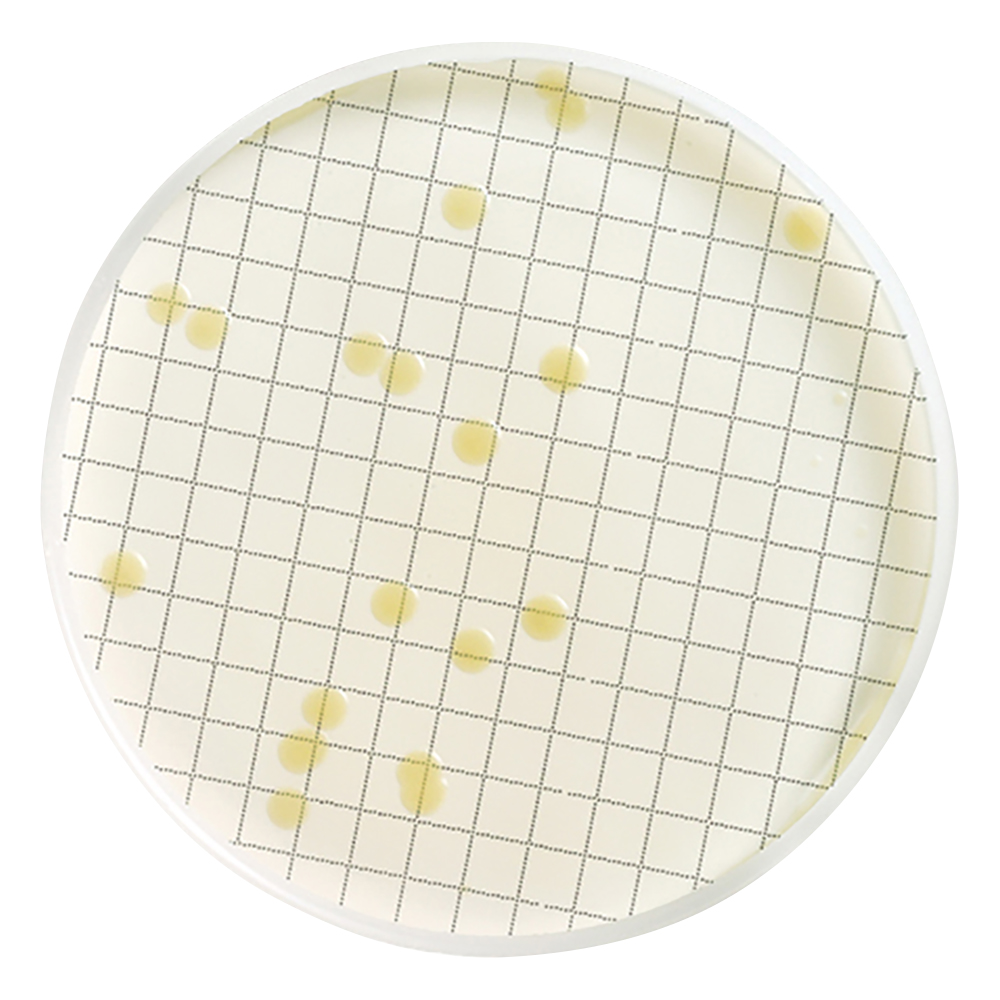
アンプル培地 （一般生菌用）1箱（50枚入）画像

培地
注文金額の合計が1,500円(税抜)以上で送料無料※北海道、沖縄、離島、一部商品を除く微生物(細菌、カビ、酵母など)や、動植物の細胞を、人工的に、増殖させる(培養する)ために、必要な、栄養分を、含んだ、液体または、固形の、基質です。研究や、検査の、目的に応じて、極めて、多種多様な、組成の培地が、使い分けられます。
業界最安級の価格
いつ買ってもおトク!
請求書払い対応
計画的なお支払いに!
小ロット・短納期
すぐ使える、すぐ届く
送料無料
注文金額の合計が1,500円(税抜)以上で送料無料
培地の人気・おすすめランキング ( もっと見る )
培地
(税込・本体代)並び順
168件中 1-50件
画像
リスト